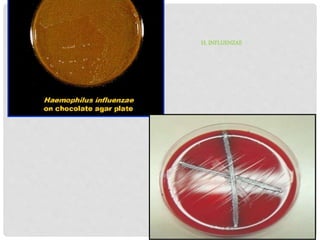
H. INFLUENZAE
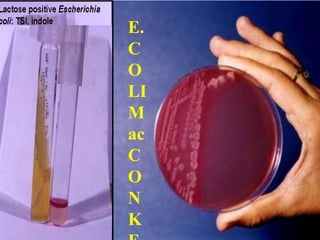
E.
C
O
LI
M
ac
C
O
N
K
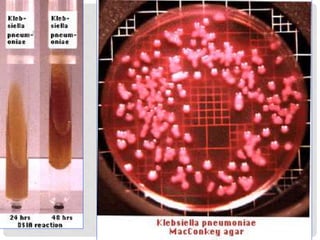
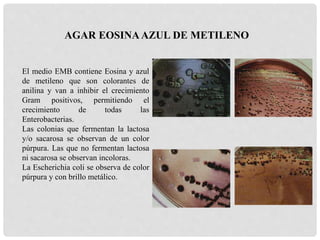
AGAR EOSINAAZUL DE METILENO
El medio EMB contiene Eosina y azul
de metileno que son colorantes de
anilina y van a inhibir el crecimiento
Gram positivos, permitiendo el
crecimiento de todas las
Enterobacterias.
Las colonias que fermentan la lactosa
y/o sacarosa se observan de un color
púrpura. Las que no fermentan lactosa
ni sacarosa se observan incoloras.
La Escherichia coli se observa de color
púrpura y con brillo metálico.
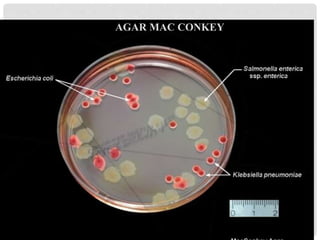
AGAR MAC CONKEY
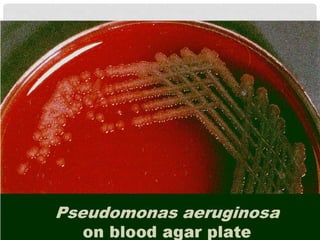
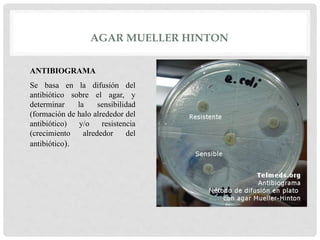
AGAR MUELLER HINTON
ANTIBIOGRAMA
Se basa en la difusión del
antibiótico sobre el agar, y
determinar la sensibilidad
(formación de halo alrededor del
antibiótico) y/o resistencia
(crecimiento alrededor del
antibiótico).
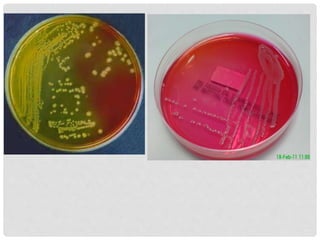
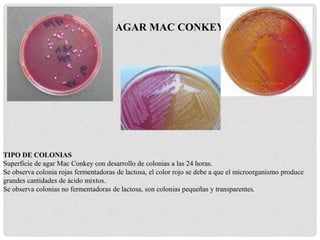
AGAR MAC CONKEY
TIPO DE COLONIAS
Superficie de agar Mac Conkey con desarrollo de colonias a las 24 horas.
Se observa colonia rojas fermentadoras de lactosa, el color rojo se debe a que el microorganismo produce
grandes cantidades de ácido mixtos.
Se observa colonias no fermentadoras de lactosa, son colonias pequeñas y transparentes.
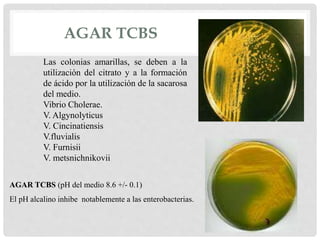
AGAR TCBS
Las colonias amarillas, se deben a la
utilización del citrato y a la formación
de ácido por la utilización de la sacarosa
del medio.
Vibrio Cholerae.
V. Algynolyticus
V. Cincinatiensis
V.fluvialis
V. Furnisii
V. metsnichnikovii
AGAR TCBS (pH del medio 8.6 +/- 0.1)
El pH alcalino inhibe notablemente a las enterobacterias.
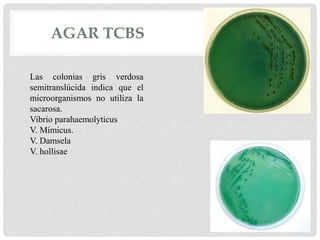
AGAR TCBS
Las colonias gris verdosa
semitranslúcida indica que el
microorganismos no utiliza la
sacarosa.
Vibrio parahaemolyticus
V. Mimicus.
V. Damsela
V. hollisae
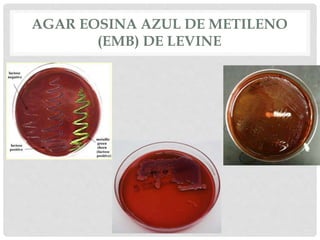
AGAR EOSINA AZUL DE METILENO
(EMB) DE LEVINE
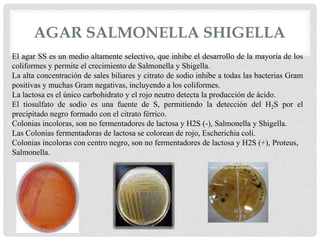
AGAR SALMONELLA SHIGELLA
El agar SS es un medio altamente selectivo, que inhibe el desarrollo de la mayoría de los
coliformes y permite el crecimiento de Salmonella y Shigella.
La alta concentración de sales biliares y citrato de sodio inhibe a todas las bacterias Gram
positivas y muchas Gram negativas, incluyendo a los coliformes.
La lactosa es el único carbohidrato y el rojo neutro detecta la producción de ácido.
El tiosulfato de sodio es una fuente de S, permitiendo la detección del H2S por el
precipitado negro formado con el citrato férrico.
Colonias incoloras, son no fermentadores de lactosa y H2S (-), Salmonella y Shigella.
Las Colonias fermentadoras de lactosa se colorean de rojo, Escherichia coli.
Colonias incoloras con centro negro, son no fermentadores de lactosa y H2S (+), Proteus,
Salmonella.
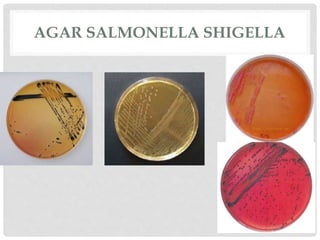
AGAR SALMONELLA SHIGELLA
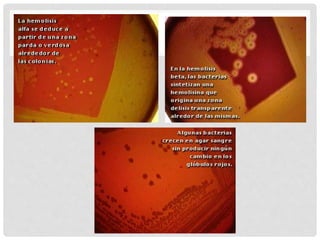
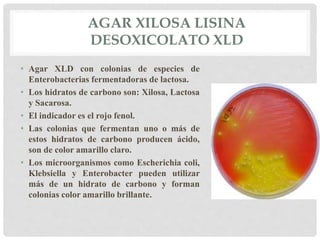
AGAR XILOSA LISINA
DESOXICOLATO XLD
• Agar XLD con colonias de especies de
Enterobacterias fermentadoras de lactosa.
• Los hidratos de carbono son: Xilosa, Lactosa
y Sacarosa.
• El indicador es el rojo fenol.
• Las colonias que fermentan uno o más de
estos hidratos de carbono producen ácido,
son de color amarillo claro.
• Los microorganismos como Escherichia coli,
Klebsiella y Enterobacter pueden utilizar
más de un hidrato de carbono y forman
colonias color amarillo brillante.

Este documento describe los requerimientos energéticos y no energéticos de los medios de cultivo para el crecimiento microbiano. Explica que los requerimientos energéticos incluyen una fuente de carbono y nitrógeno, mientras que los no energéticos incluyen fuentes de azufre, fósforo, iones metálicos y factores de crecimiento. También clasifica los medios de cultivo según su consistencia en sólidos, líquidos y semisólidos, y proporciona ejemplos como el agar sang